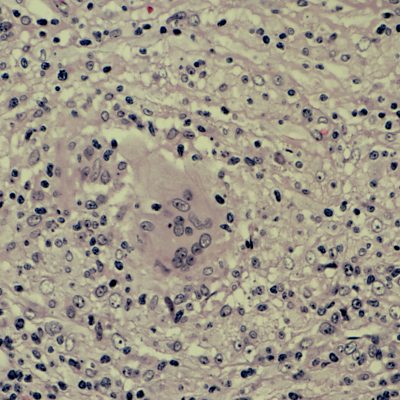

Episode details
Available for over a year
In the week that the US Centers for Disease Control and Prevention said that leprosy could now be endemic in the South-eastern United States, Claudia Hammond looks at global action on leprosy with science journalist Kamala Thiagarajan. There is an international effort to learn more about weaning seriously ill people off ventilator support in hospitals. We hear about the Weansafe study from Ireland. Professor of integrated community child health at University College London, Monica Lakhanpaul joins Claudia in the studio to discuss why the roll out of a new vaccine for RSV (Respiratory Syncytial Virus) in the US could be a gamechanger. And why on your next trip to a hospital, you could see groups of elderly in-patients going on walks. Could it help prevent the effects of bedrest? Image: Leprosy, nerve biopsy, nerve fibres surrounded by histiocytes Presenter: Claudia Hammond Producer: Clare Salisbury
Programme Website